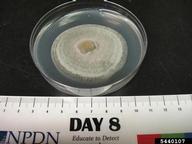
Top of plate, 8 days of growth in alternating 12 hours light/dark cycle, grown at 25C

Gerald Holmes, Strawberry Center, Cal Poly San Luis Obispo, Bugwood.org
Foliar symptoms. October 1997

Jason Brock, University of Georgia, Bugwood.org
Corynespora leaf spot (Corynespora cassiicola) symptoms on cotton (Gossypium hirsutum)

Gerald Holmes, Strawberry Center, Cal Poly San Luis Obispo, Bugwood.org
Leaf spots. August 1999

Yuan-Min Shen, National Taiwan University, Bugwood.org
black lesions with conidia
Samuel Glucksman, Bugwood.org
Top of plate, 8 days of growth in alternating 12 hours light/dark cycle, grown at 25C

Fred Brooks, University of Hawaii at Manoa, Bugwood.org
conidiospores and hyphae

Jason Brock, University of Georgia, Bugwood.org
conidia

Jason Brock, University of Georgia, Bugwood.org
conidia